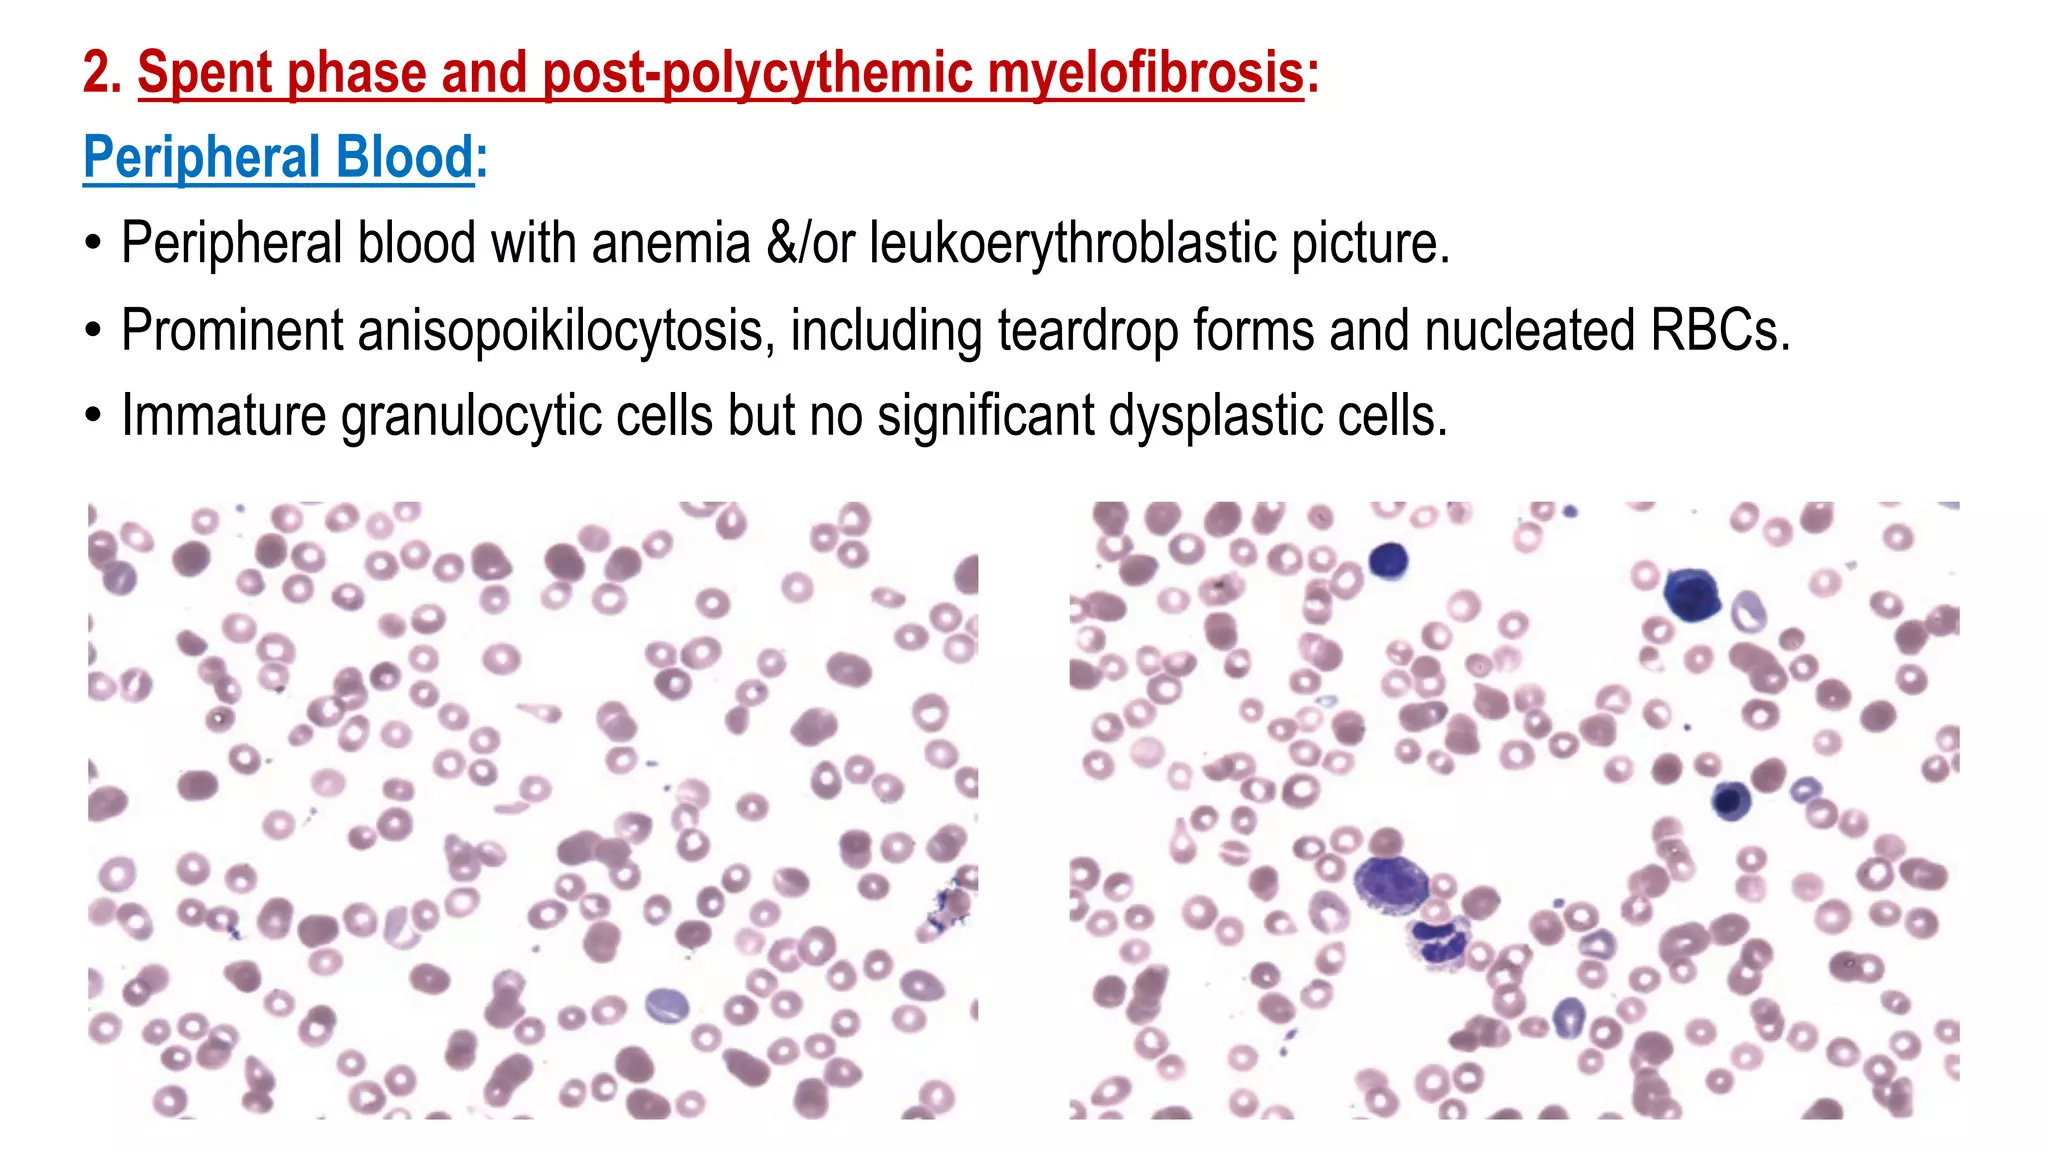
2. Spent phase and post-polycythemic myelofibrosis:
Peripheral Blood:
• Peripheral blood with anemia &/or leukoerythroblastic picture.
• Prominent anisopoikilocytosis, including teardrop forms and nucleated RBCs.
• Immature granulocytic cells but no significant dysplastic cells.
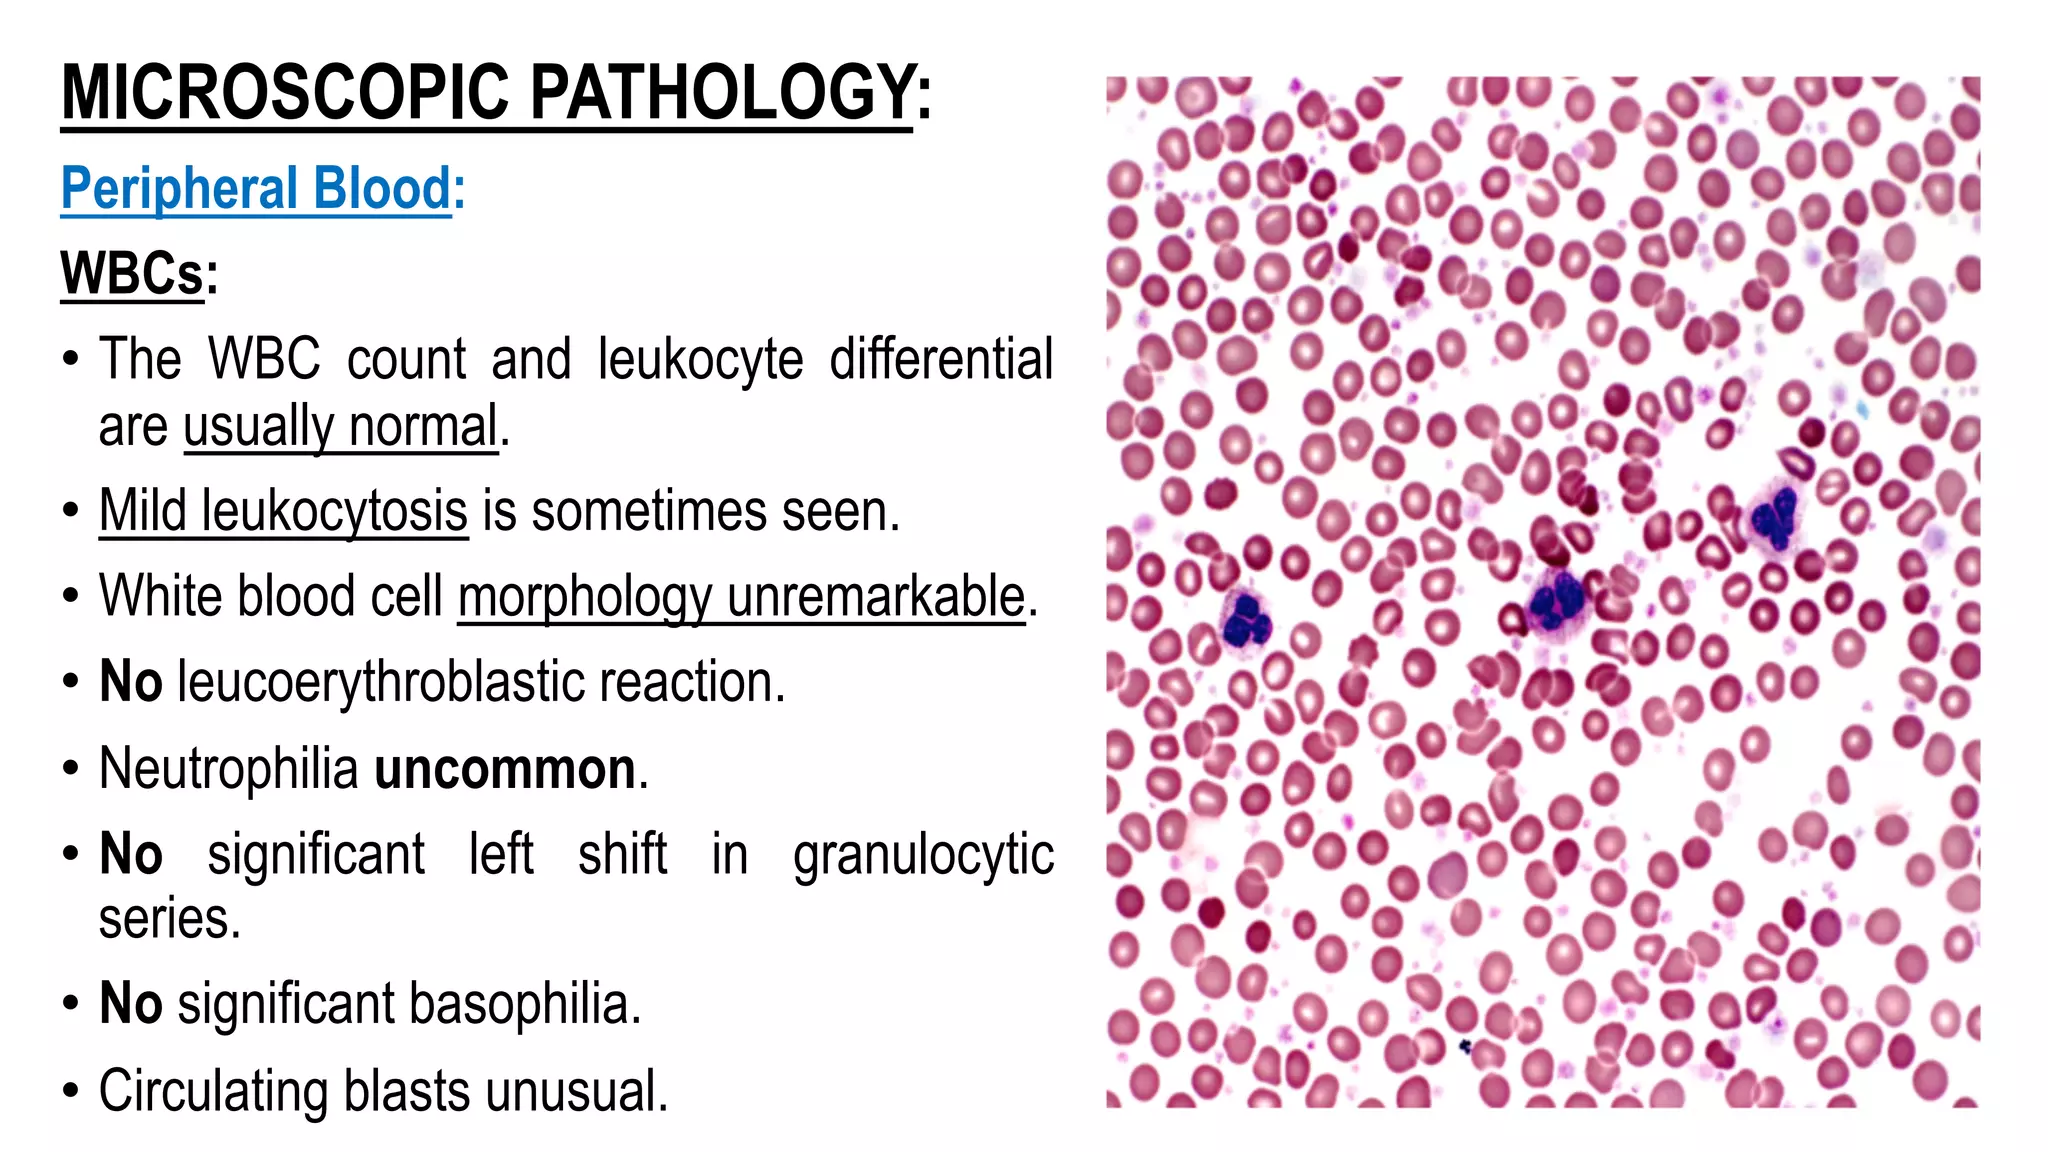
MICROSCOPIC PATHOLOGY:
Peripheral Blood:
WBCs:
• The WBC count and leukocyte differential
are usually normal.
• Mild leukocytosis is sometimes seen.
• White blood cell morphology unremarkable.
• No leucoerythroblastic reaction.
• Neutrophilia uncommon.
• No significant left shift in granulocytic
series.
• No significant basophilia.
• Circulating blasts unusual.
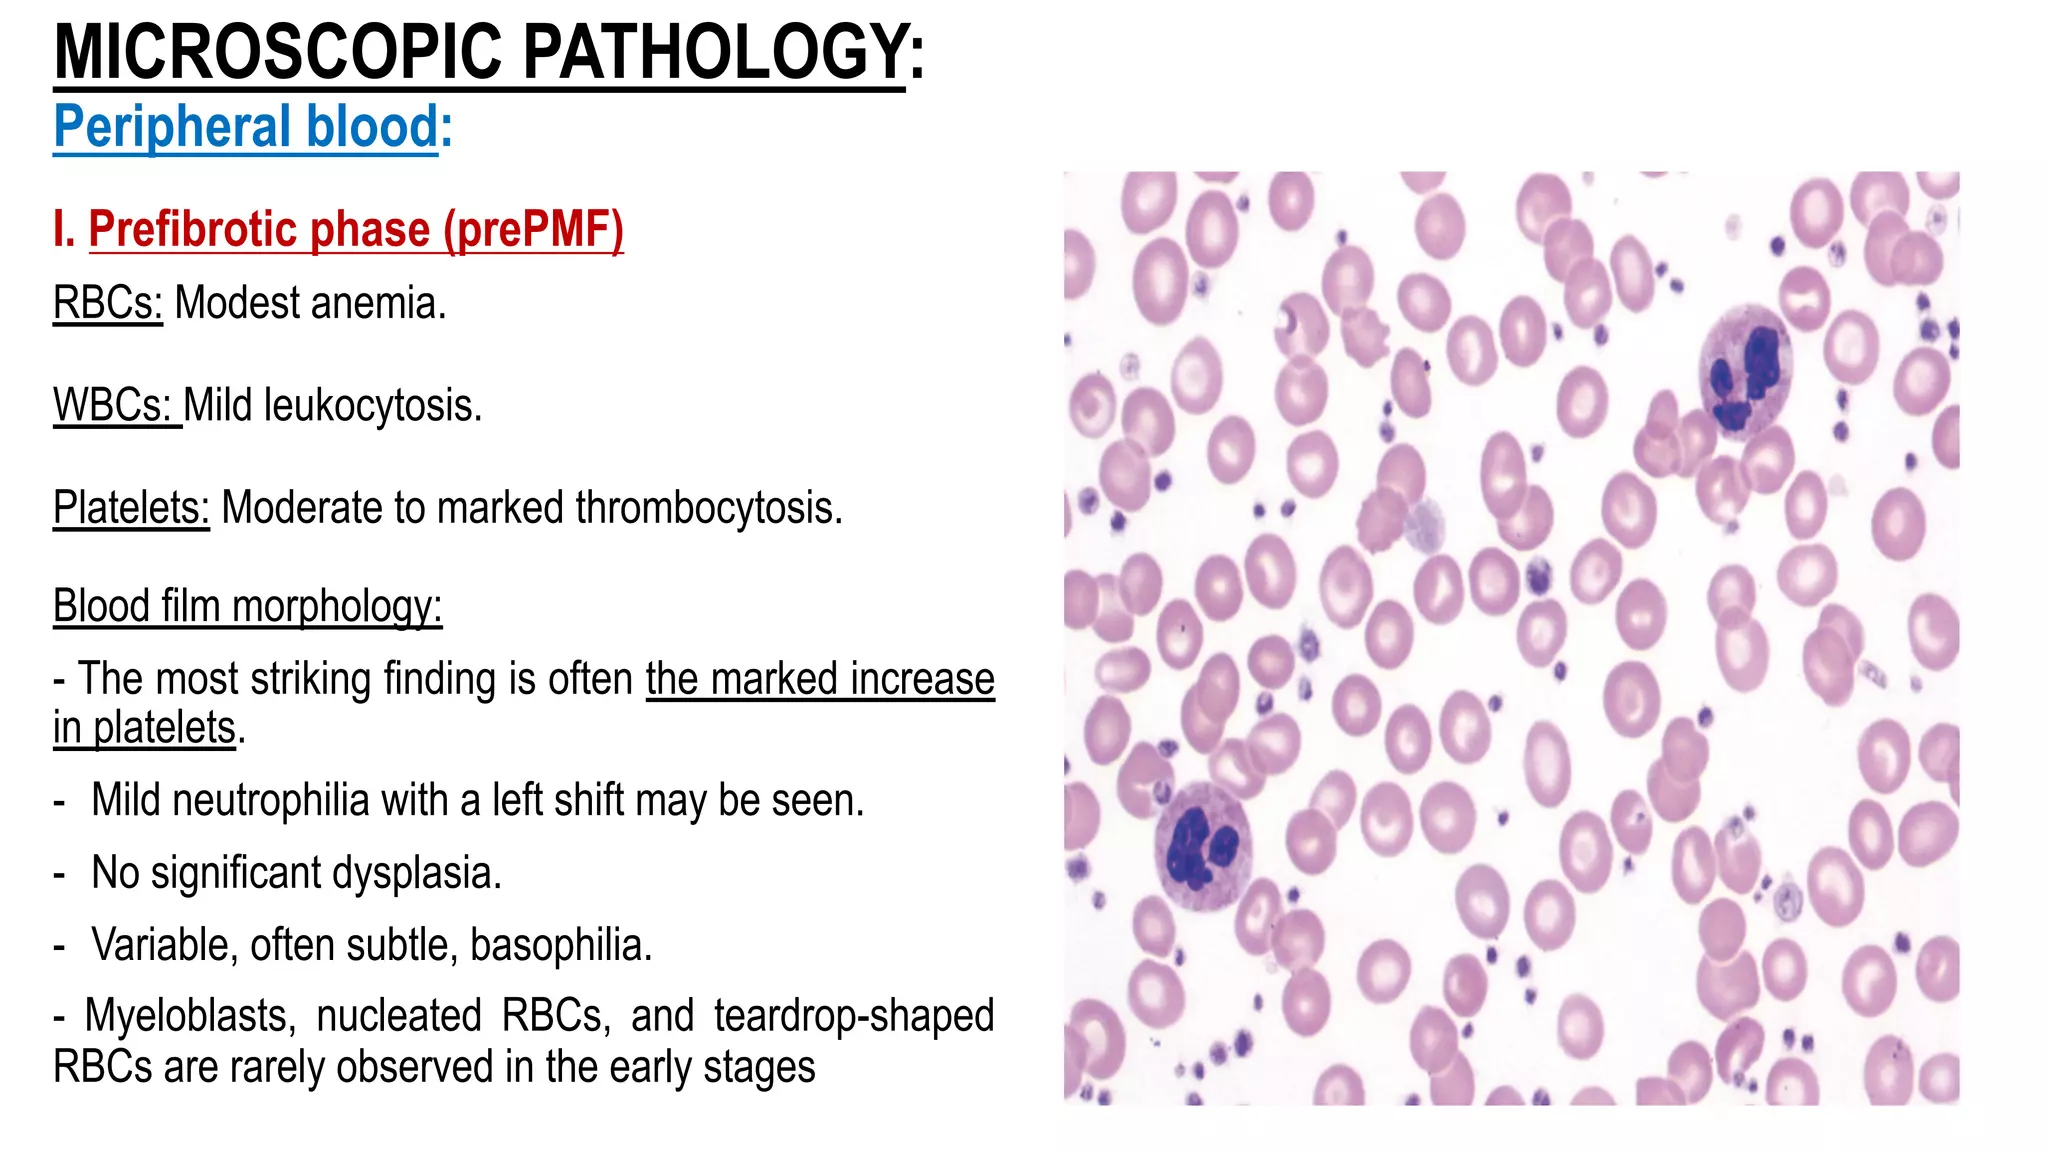
MICROSCOPIC PATHOLOGY:
Peripheral blood:
I. Prefibrotic phase (prePMF)
RBCs: Modest anemia.
WBCs: Mild leukocytosis.
Platelets: Moderate to marked thrombocytosis.
Blood film morphology:
- The most striking finding is often the marked increase
in platelets.
- Mild neutrophilia with a left shift may be seen.
- No significant dysplasia.
- Variable, often subtle, basophilia.
- Myeloblasts, nucleated RBCs, and teardrop-shaped
RBCs are rarely observed in the early stages

MPNs are clonal hematopoietic stem cell disorders characterized by overproduction of one or more myeloid cell lineages in the bone marrow and blood. The key subtypes include CML, PV, PMF, and ET. CML is driven by the Philadelphia chromosome and BCR-ABL1 fusion gene. PV is characterized by elevated red blood cell counts and the JAK2 V617F mutation in over 95% of cases. Without treatment, MPNs can progress to more advanced stages including myelofibrosis, leukemia, or transformation. Molecular testing plays an important role in diagnosis and classification.